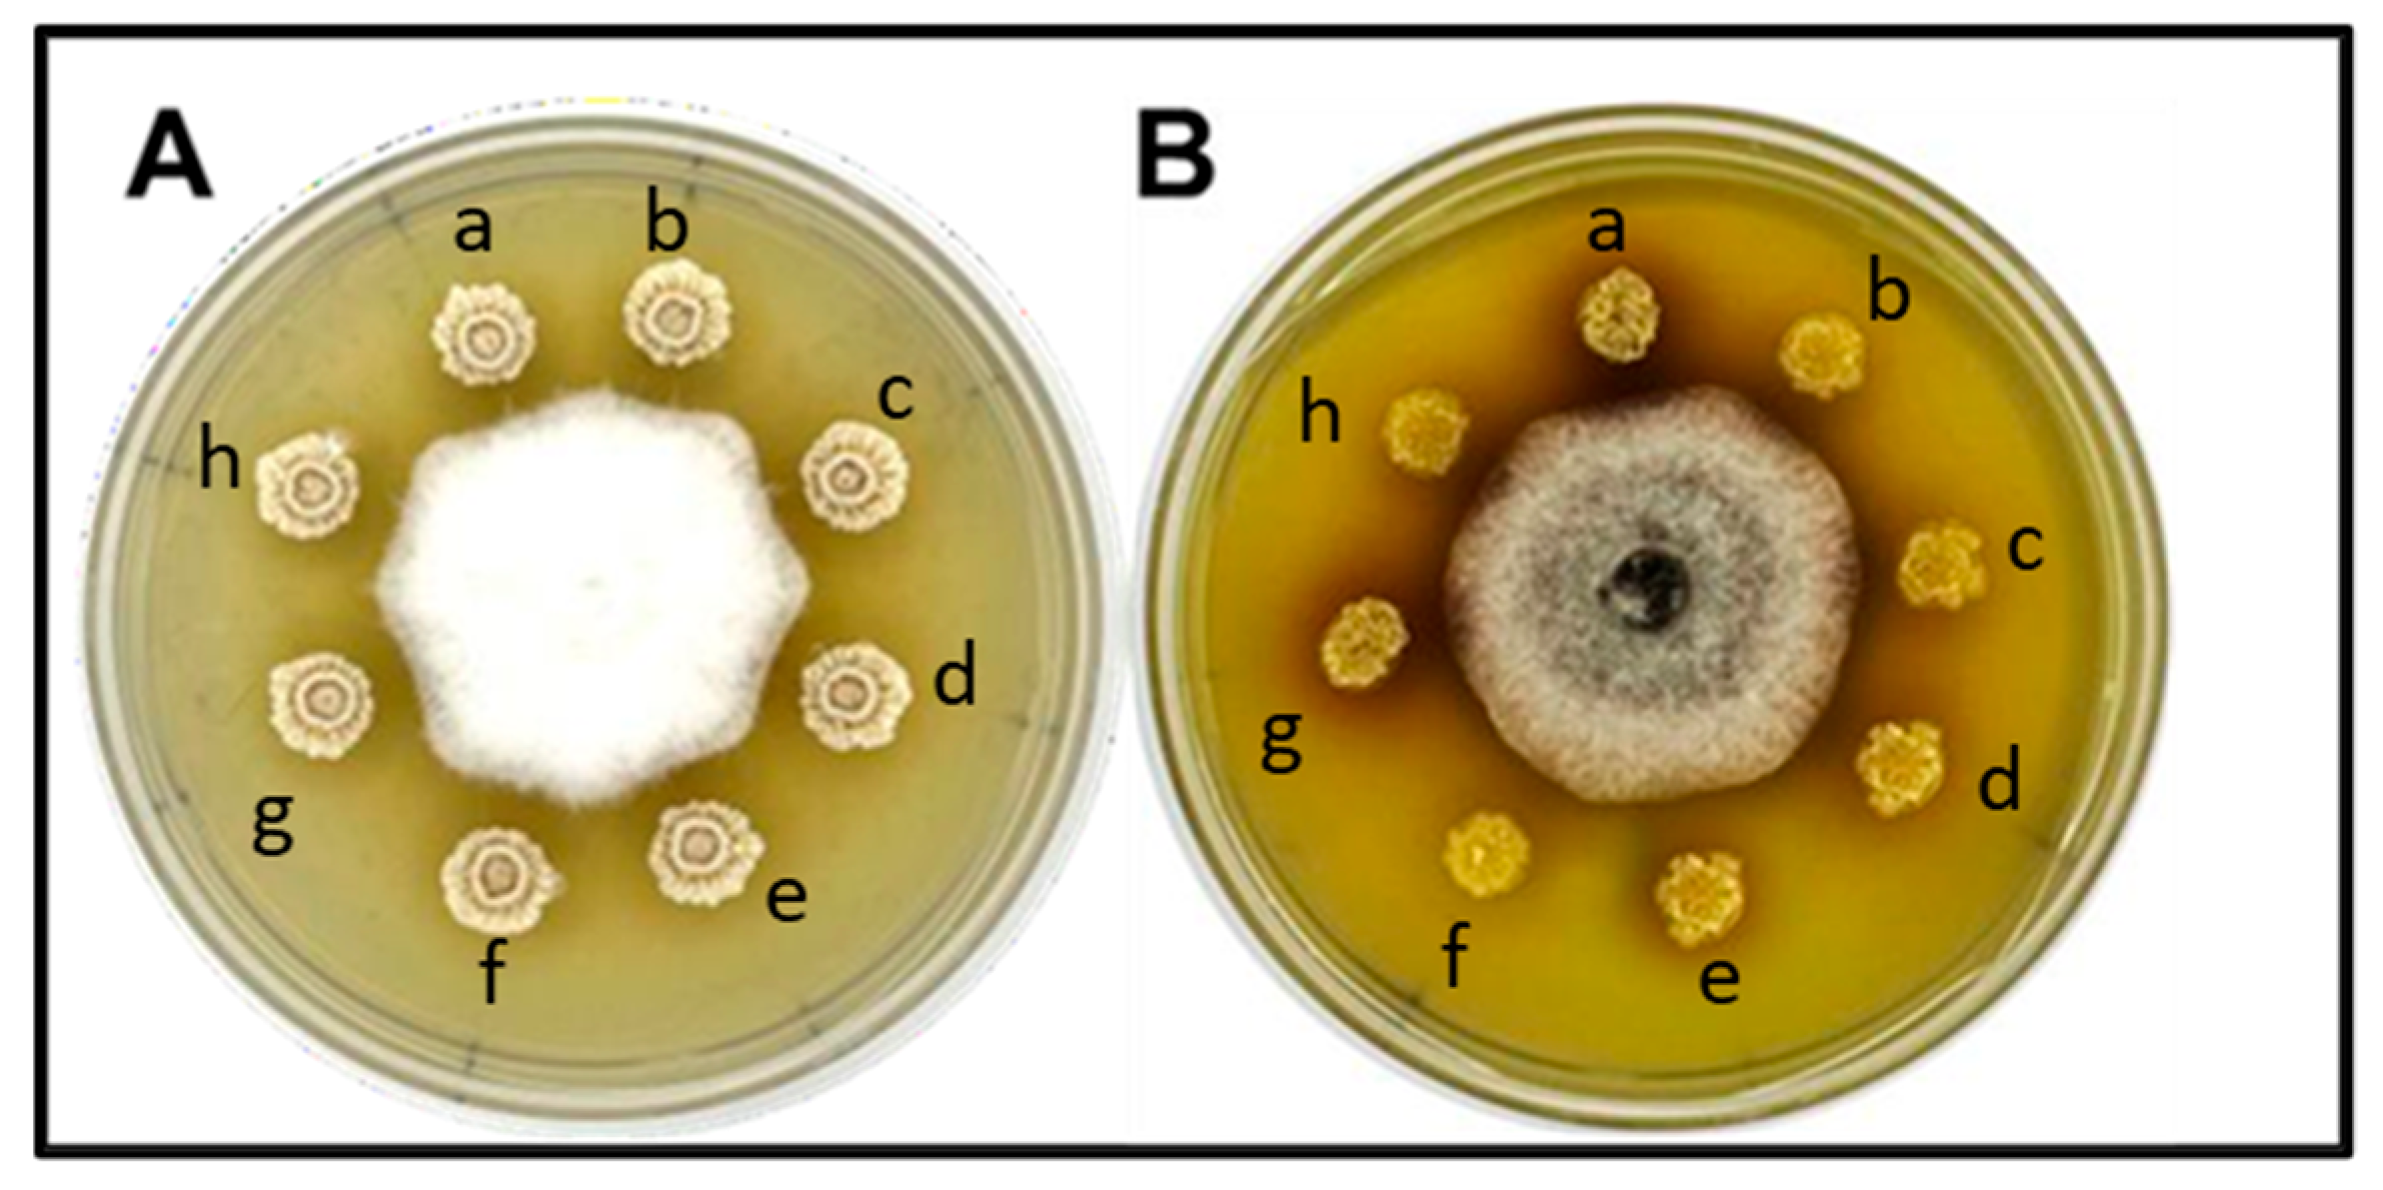
Microbiolres 15 00159 g003 Microbiolres 15 00159 g003

Biological Traits of Vertically Seed-Transmitted Bacillus mojavensis in Triticum aestivum L.
Abstract
1. Introduction
2. Materials and Methods
2.1. Microbial Strains and Growth Conditions
2.2. Rifampicin-Resistant B. mojavensis PS17 Preparation
2.3. Verification of Rifampicin Resistance Specificity
2.4. Bacterial Cell Suspension Preparation
2.4.1. Vertical Transmission of B. mojavensis PS17
2.4.2. Screening for B. mojavensis PS17 in Wheat
2.5. DNA Fingerprinting Analysis
2.6. Molecular Identification of Selected Bacterial Isolates
2.7. The Antagonistic Activity of the Selected Bacterial Isolates Against Phytopathogens
2.8. Hydrolytic Enzyme Production by Selected Bacterial Isolates
3. Results
3.1. The Ability of B. mojavensis PS17 to Pass into Next-Generation Plants
3.2. Biological Traits of B. mojavensis PS17 Seed-Transmitted Colonies
3.2.1. The Antagonistic Activity of the Isolated Bacteria Against Phytopathogens
3.2.2. Hydrolytic Enzyme Production by Selected Bacterial Strains
3.3. DNA Fingerprinting Analysis and Molecular Identification of Seed-Isolated Bacterial Strains
4. Discussion
5. Conclusions
Author Contributions
Funding
Institutional Review Board Statement
Informed Consent Statement
Data Availability Statement
Conflicts of Interest
References
- Yildirim, E.; Dursun, A.; Kumlay, M.A.; Güvenç, Í. The effects of different salt, biostimulants, and temperature levels on seed germination of some vegetable species. Acta Agrobot. 2002, 55, 75–80. [Google Scholar] [CrossRef]
- Bulgari, R.; Franzoni, G.; Ferrante, A. Biostimulants Application in Horticultural Crops under Abiotic Stress Conditions. Agronomy 2019, 9, 306. [Google Scholar] [CrossRef]
- Savvides, A.; Ali, S.; Tester, M.; Fotopoulos, V. Chemical Priming of Plants Against Multiple Abiotic Stresses: Mission Possible? Trends Plant Sci. 2016, 21, 329–340. [Google Scholar] [CrossRef]
- Moumni, M.; Brodal, G.; Romanazzi, G. Recent innovative seed treatment methods in the management of seed-borne pathogens. Food Sec. 2023, 15, 1365–1382. [Google Scholar] [CrossRef]
- Sharma, K.K.; Singh, U.S.; Sharma, P.; Kumar, A.; Sharma, L. Seed treatments for sustainable agriculture—A review. J. Appl. Nat. Sci. 2015, 7, 521–539. [Google Scholar] [CrossRef]
- Ibrahim, E.A. Seed priming to alleviate salinity stress in germinating seeds. J. Plant Physiol. 2016, 192, 38–46. [Google Scholar] [CrossRef] [PubMed]
- Paparella, S.; Araújo, S.S.; Rossi, G.; Wijayasinghe, M.; Carbonera, D.; Balestrazzi, A. Seed priming: State of the art and new perspectives. Plant Cell Rep. 2015, 34, 1281–1293. [Google Scholar] [CrossRef]
- Sturz, A.V.; Christie, B.R.; Nowak, J. Bacterial endophytes: Potential role in developing sustainable systems of crop production. Crit. Rev. Plant Sci. 2000, 19, 1–30. [Google Scholar] [CrossRef]
- Shen, F.T.; Yen, J.H.; Liao, C.S.; Chen, W.C.; Chao, Y.T. Screening of Rice Endophytic Biofertilizers with Fungicide Tolerance and Plant Growth-Promoting Characteristics. Sustainability 2019, 11, 1133. [Google Scholar] [CrossRef]
- Kloepper, J.W.; Ryu, C.M. Bacterial Endophytes as Elicitors of Induced Systemic Resistance. In Microbial Root Endophytes, Soil Biology; Schulz, B.J.E., Boyle, C.J.C., Sieber, T.N., Eds.; Springer: Berlin/Heidelberg, Germany, 2006; pp. 33–52. [Google Scholar] [CrossRef]
- Gouda, S.; Das, G.; Sen, S.K.; Shin, H.S.; Patra, J.K. Endophytes: A Treasure House of Bioactive Compounds of Medicinal Importance. Front. Microbiol. 2016, 7, 1538. [Google Scholar] [CrossRef]
- Khare, E.; Mishra, J.; Arora, N.K. Multifaceted Interactions Between Endophytes and Plant: Developments and Prospects. Front. Microbiol. 2018, 9, 2732. [Google Scholar] [CrossRef]
- White, J.F.; Kingsley, K.L.; Zhang, Q.; Verma, R.; Obi, N.; Dvinskikh, S.; Elmore, M.T.; Verma, S.K.; Gond, S.K.; Kowalski, K.P. Review: Endophytic microbes and their potential applications in crop management. Pest Manag. Sci. 2019, 75, 2558–2565. [Google Scholar] [CrossRef] [PubMed]
- Goggin, D.E.; Emery, R.J.N.; Kurepin, L.V.; Powles, S.B. A potential role for endogenous microflora in dormancy release, cytokinin metabolism, and the response to fluridone in Lolium rigidum seeds. Ann. Bot. 2015, 115, 293–301. [Google Scholar] [CrossRef]
- Puente, M.E.; Li, C.Y.; Bashan, Y. Endophytic bacteria in cacti seeds can improve the development of cactus seedlings. Environ. Exp. Bot. 2009, 66, 402–408. [Google Scholar] [CrossRef]
- Rout, M.E.; Chrzanowski, T.H.; Westlie, T.K.; Deluca, T.H.; Callaway, R.M.; Holben, W.E. Bacterial endophytes enhance competition by invasive plants. Am. J. Bot. 2013, 100, 1726–1737. [Google Scholar] [CrossRef]
- Verma, H.; Kumar, D.; Kumar, V.; Kumari, M.; Singh, S.K.; Sharma, V.K.; Droby, S.; Santoyo, G.; White, J.F.; Kumar, A. The Potential Application of Endophytes in Management of Stress from Drought and Salinity in Crop Plants. Microorganisms 2021, 9, 1729. [Google Scholar] [CrossRef]
- Senthilkumar, M.; Anandham, R.; Madhaiyan, M.; Venkateswaran, V.; Sa, T. Endophytic Bacteria: Perspectives and Applications in Agricultural Crop Production. In Bacteria in Agrobiology: Crop Ecosystems; Maheshwari, D.K., Ed.; Springer: Berlin/Heidelberg, Germany, 2011; pp. 61–96. [Google Scholar] [CrossRef]
- Wu, W.; Chen, W.; Liu, S.; Wu, J.; Zhu, Y.; Qin, L.; Zhu, B. Beneficial relationships between endophytic bacteria and medicinal plants. Front. Plant Sci. 2021, 12, 646146. [Google Scholar] [CrossRef]
- Frank, A.C.; Saldierna Guzmán, J.P.; Shay, J.E. Transmission of Bacterial Endophytes. Microorganisms 2017, 5, 70. [Google Scholar] [CrossRef]
- Hallmann, J.; Quadt-Hallmann, A.; Mahaffee, W.F.; Kloepper, J.W. Bacterial endophytes in agricultural crops. Can. J. Microbiol. 1997, 43, 895–914. [Google Scholar] [CrossRef]
- Firáková, S.; Šturdíková, M.; Múčková, M. Bioactive secondary metabolites produced by microorganisms associated with plants. Biologia 2007, 62, 251–257. [Google Scholar] [CrossRef]
- Truyens, S.; Weyens, N.; Cuypers, A.; Vangronsveld, J. Bacterial seed endophytes genera, vertical transmission and interaction with plants. Environ. Microbiol. Rep. 2015, 7, 40–50. [Google Scholar] [CrossRef]
- Carroll, G. Fungal endophytes in stems and leaves: From latent pathogen to mutualistic symbiont. Ecology 1988, 69, 2–9. [Google Scholar] [CrossRef]
- Nelson, E.B. The seed microbiome: Origins, interactions, and impacts. Plant Soil 2018, 422, 7–34. [Google Scholar] [CrossRef]
- Abdelfattah, A.; Tack, A.J.; Lobato, C.; Wassermann, B.; Berg, G. From seed to seed: The role of microbial inheritance in the assembly of the plant microbiome. Trends Microbiol. 2023, 31, 346–355. [Google Scholar] [CrossRef]
- Elbeltagy, A.; Nishioka, K.; Suzuki, H.; Sato, T.; Sato, Y.I.; Morisaki, H.; Minamisawa, K. Isolation and characterization of endophytic bacteria from wild and traditionally cultivated rice varieties. Soil Sci. Plant Nutr. 2000, 46, 617–629. [Google Scholar] [CrossRef]
- Mano, H.; Tanaka, F.; Watanabe, A.; Kaga, H.; Okunishi, S.; Morisaki, H. Culturable surface and endophytic bacterial flora of the maturing seeds of rice plants (Oryza sativa) cultivated in a paddy field. Microbes Environ. 2006, 21, 86–100. [Google Scholar] [CrossRef]
- Kandel, S.L.; Joubert, P.M.; Doty, S.L. Bacterial endophyte colonization and distribution within plants. Microorganisms 2017, 5, 77. [Google Scholar] [CrossRef]
- Diabankana, R.G.C.; Afordoanyi, D.M.; Safin, R.I.; Nizamov, R.M.; Karimova, L.Z.; Validov, S.Z. Antifungal properties, abiotic stress resistance, and biocontrol ability of Bacillus mojavensis PS17. Curr. Microbiol. 2021, 78, 3124–3132. [Google Scholar] [CrossRef]
- Glandorf, D.C.M.; Brand, I.; Bakker, P.A.H.M. Stability of rifampicin resistance as a marker for root colonization studies of Pseudomonas putida in field. Plant Soil 1992, 147, 135–142. [Google Scholar] [CrossRef]
- Simons, M.; Van Der Bij, A.J.; Brand, I.; De Weger, L.A.; Wijffelman, C.A.; Lugtenberg, B.J. Gnotobiotic system for studying rhizosphere colonization by plant growth-promoting Pseudomonas bacteria. Mol. Plant-Microbe Interact. MPMI 1996, 9, 600–607. [Google Scholar] [CrossRef]
- Mohkam, M.; Nezafat, N.; Berenjian, A.; Mobasher, M.A.; Ghasemi, Y. Identification of Bacillus probiotics isolated from soil rhizosphere using 16S rRNA, recA, and rpoB gene sequencing and RAPD-PCR. Probiotics Antimicrob. Proteins 2016, 8, 8–18. [Google Scholar] [CrossRef]
- Lane, D.J.; Pace, B.; Olsen, G.J.; Stahl, D.A.; Sogin, M.L.; Pace, N.R. Rapid determination of 16S ribosomal RNA sequences for phylogenetic analyses. Proc. Natl. Acad. Sci. USA 1985, 82, 6955–6959. [Google Scholar] [CrossRef] [PubMed]
- Ki, J.S.; Zhang, W.; Qian, P.Y. Discovery of marine Bacillus species by 16S rRNA and rpoB comparisons and their usefulness for species identification. J. Microbiol. Methods 2009, 77, 48–57. [Google Scholar] [CrossRef] [PubMed]
- Chun, J.; Bae, K.S. Phylogenetic analysis of Bacillus subtilis and related taxa based on partial gyrA gene sequences. Antonie Van Leeuwenhoek 2000, 78, 123–127. [Google Scholar] [CrossRef] [PubMed]
- Kumar, A.; Droby, S.; Singh, V.K.; Singh, S.K.; White, J.F. Entry, colonization, and distribution of endophytic microorganisms in plants. In Microbial Endophytes; Kumar, A., Radhakrishnan, E.K., Eds.; Woodhead Publishing: Cambridge, UK, 2020; pp. 1–33. [Google Scholar] [CrossRef]
- Prieto, P.; Schilirò, E.; Maldonado-González, M.M.; Valderrama, R.; Barroso-Albarracín, J.B.; Mercado-Blanco, J. Root Hairs Play a Key Role in the Endophytic Colonization of Olive Roots by Pseudomonas spp. with Biocontrol Activity. Microb. Ecol. 2011, 62, 435–445. [Google Scholar] [CrossRef]
- Liu, H.; Carvalhais, L.C.; Crawford, M.; Singh, E.; Dennis, P.G.; Pieterse, C.M.J.; Schenk, P.M. Inner Plant Values: Diversity, Colonization and Benefits from Endophytic Bacteria. Front. Microbiol. 2017, 8, 2552. [Google Scholar] [CrossRef] [PubMed]
- De Weert, S.; Vermeiren, H.; Mulders, I.H.M.; Kuiper, I.; Hendrickx, N.; Bloemberg, G.V.; Vanderleyden, J.; De Mot, R.; Lugtenberg, B.J.J. Flagella-Driven Chemotaxis Towards Exudate Components Is an Important Trait for Tomato Root Colonization by Pseudomonas fluorescens. Mol. Plant Microbe Interact. 2002, 15, 1173–1180. [Google Scholar] [CrossRef]
- Bacilio-Jiménez, M.; Aguilar-Flores, S.; Ventura-Zapata, E.; Pérez-Campos, E.; Bouquelet, S.; Zenteno, E. Chemical characterization of root exudates from rice (Oryza sativa) and their effects on the chemotactic response of endophytic bacteria. Plant Soil 2003, 249, 271–277. [Google Scholar] [CrossRef]
- Compant, S.; Clément, C.; Sessitsch, A. Plant growth-promoting bacteria in the rhizo- and endosphere of plants: Their role, colonization, mechanisms involved and prospects for utilization. Soil Biol. Biochem. 2010, 42, 669–678. [Google Scholar] [CrossRef]
- Rosenblueth, M.; Martínez-Romero, E. Bacterial Endophytes and Their Interactions with Hosts. Mol. Plant Microbe Interact. 2006, 19, 827–837. [Google Scholar] [CrossRef]
- Walitang, D.; Kim, C.G.; Jeon, S.; Kang, Y.; Sa, T. Conservation and transmission of seed bacterial endophytes across generations following crossbreeding and repeated inbreeding of rice at different geographic locations. MicrobiologyOpen 2019, 8, e00662. [Google Scholar] [CrossRef] [PubMed]
- Podile, A.R.; Vukanti, R.; Ankati, S.; Kalam, S.; Dutta, S.; Durgeshwar, P.; Vaikuntapu, P. Root Colonization and Quorum Sensing are the Driving forces of Plant Growth Promoting Rhizobacteria (pgpr) for Growth Promotion. Proc. Indian Natl. Sci. Acad. 2014, 80, 407. [Google Scholar] [CrossRef]
- Samreen, T.; Naveed, M.; Nazir, M.Z.; Asghar, H.N.; Khan, M.I.; Zahir, Z.A.; Choudhary, M. Seed associated bacterial and fungal endophytes: Diversity, life cycle, transmission, and application potential. Appl. Soil Ecol. 2021, 168, 104191. [Google Scholar] [CrossRef]
- Paravar, A.; Piri, R.; Balouchi, H.; Ma, Y. Microbial seed coating: An attractive tool for sustainable agriculture. Biotechnol. Rep. 2023, 37, e00781. [Google Scholar] [CrossRef]
- Wulff, E.G.; Van Vuurde, J.W.L.; Hockenhull, J. The ability of the biological control agent Bacillus subtilis, strain BB, to colonise vegetable brassicas endophytically following seed inoculation. Plant Soil 2003, 255, 463–474. [Google Scholar] [CrossRef]
- Shahzad, R.; Khan, A.L.; Bilal, S.; Asaf, S.; Lee, I.J. What Is There in Seeds? Vertically Transmitted Endophytic Resources for Sustainable Improvement in Plant Growth. Front. Plant Sci. 2018, 9, 24. [Google Scholar] [CrossRef]
- Bochner, B.R. Global phenotypic characterization of bacteria. FEMS Microbiol. Rev. 2008, 33, 191–205. [Google Scholar] [CrossRef]
- Ackermann, M. A functional perspective on phenotypic heterogeneity in microorganisms. Nat. Rev. Microbiol. 2015, 13, 497–508. [Google Scholar] [CrossRef]
- Troxler, J.; Zala, M.; Natsch, A.; Moënne-Loccoz, Y.; Défago, G. Autecology of the biocontrol strain Pseudomonas fluorescens CHA0 in the rhizosphere and inside roots at later stages of plant development. FEMS Microbiol. Ecol. 2006, 23, 119–130. [Google Scholar] [CrossRef][Green Version]
- Barnett, S.; Singleton, I.; Ryder, M.; Ogoshi, A.; Kobayashi, K.; Homma, Y.; Akino, S. The effect of growth conditions on phenotype plasticity in Pseudomonas corrugata 2140, and the phenotypic characterisation of a range of new phenotype variants. In Proceedings of the Fourth International Workshop on the Plant Growth-Promoting Rhizobacteria, Sapporo, Japan, 5–10 October 1997; Ogoshi, A., Kobayashi, K., Homma, Y., Kodama, F., Kondo, N., Akino, S., Eds.; Hokkaido University: Sapporo, Japan, 1997; pp. 417–420. [Google Scholar]
- Marques, A.S.A.; Marchaison, A.; Gardan, L.; Samson, R. BOX-PCR-Based Identification of Bacterial Species Belonging to Pseudomonas Syringae—P. Viridiflava Group. Available online: https://www.scielo.br/pdf/gmb/v31n1/19.pdf (accessed on 20 September 2024).
- Tacão, M.; Alves, A.; Saavedra, M.J.; Correia, A. BOX-PCR Is an Adequate Tool for Typing Aeromonas spp. Available online: https://link.springer.com/article/10.1007/s10482-005-3450-9 (accessed on 20 September 2024).

| Microbial Strains | Source | Reference |
|---|---|---|
| B. mojavensis PS17 | From wheat seed | [30] |
| B. mojavensis PS17 (Rif100) | Rifampicin-resistant PS17 at 100 μg/mL | In this study |
| Bacillus amyloliquefaciens | From rhizosphere winter wheat | * |
| Bacillus halotolerans | * | |
| Bacillus sp. | * | |
| F. oxysporium | From onion (Allium cepa L.) | * |
| A. alternata | From spring wheat seed | * |
| Target Genes | Oligonucleotide | Annealing Temperature | Reference |
|---|---|---|---|
| recA | 5′-GATCGTCAAGCAGCCTTAGAT-3′ | 55 °C | [33] |
| 5′-TTACCGACCATAACGCCGAC-3′ | |||
| 16S rRNA | 5′-AGAGTTTGATCMTGGCTCAG-3′ | 58 °C | [34] |
| 5′-AAGGAGGTGATCCAGCCGCA-3′ | |||
| rpoB | 5′-ATCGAAACGCCTGAAGGTCCAAACAT-3′ | 58 °C | [35] |
| 5′-ACACCCTTGTACCGTGACGACC-3′ | |||
| gyrA | 5′-CAGTCAGGAAATGCGTACGTCCTT -3′ | 58 °C | [36] |
| 5′-CAAGGTAATGCTCCAGGCATTGCT -3′ |
Disclaimer/Publisher’s Note: The statements, opinions and data contained in all publications are solely those of the individual author(s) and contributor(s) and not of MDPI and/or the editor(s). MDPI and/or the editor(s) disclaim responsibility for any injury to people or property resulting from any ideas, methods, instructions or products referred to in the content. |
© 2024 by the authors. Licensee MDPI, Basel, Switzerland. This article is an open access article distributed under the terms and conditions of the Creative Commons Attribution (CC BY) license (https://creativecommons.org/licenses/by/4.0/).
Share and Cite
Diabankana, R.G.C.; Afordoanyi, D.M.; Filimonova, M.N.; Validov, S.Z.; Safin, R.I. Biological Traits of Vertically Seed-Transmitted Bacillus mojavensis in Triticum aestivum L. Microbiol. Res. 2024, 15, 2369-2380. https://doi.org/10.3390/microbiolres15040159
Diabankana RGC, Afordoanyi DM, Filimonova MN, Validov SZ, Safin RI. Biological Traits of Vertically Seed-Transmitted Bacillus mojavensis in Triticum aestivum L. Microbiology Research. 2024; 15(4):2369-2380. https://doi.org/10.3390/microbiolres15040159
Chicago/Turabian StyleDiabankana, Roderic Gilles Claret, Daniel Mawuena Afordoanyi, Maria Nikolaevna Filimonova, Shamil Zavdatovich Validov, and Radik Ilyasovich Safin. 2024. "Biological Traits of Vertically Seed-Transmitted Bacillus mojavensis in Triticum aestivum L." Microbiology Research 15, no. 4: 2369-2380. https://doi.org/10.3390/microbiolres15040159
APA StyleDiabankana, R. G. C., Afordoanyi, D. M., Filimonova, M. N., Validov, S. Z., & Safin, R. I. (2024). Biological Traits of Vertically Seed-Transmitted Bacillus mojavensis in Triticum aestivum L. Microbiology Research, 15(4), 2369-2380. https://doi.org/10.3390/microbiolres15040159

